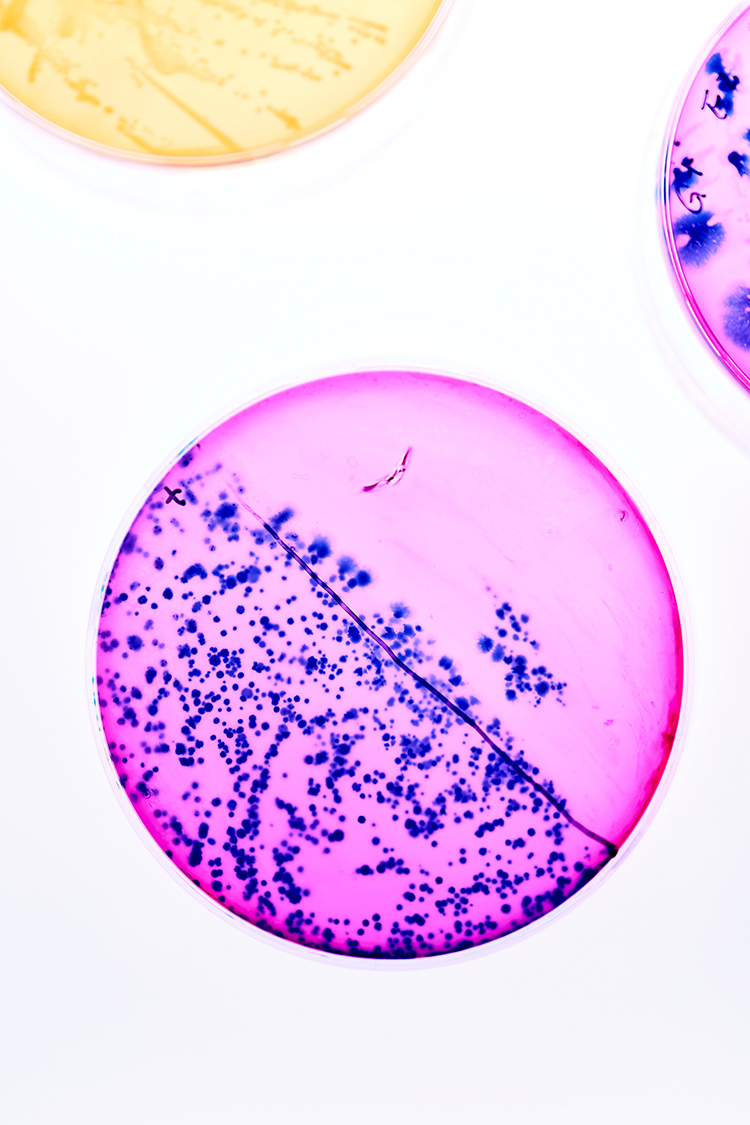

FPP Amsterdam 2025 Speaker Interview: Navigating the regulatory maze – how Unibio is scaling single-cell protein for a global market
As the alternative protein industry races to commercialize bold new ideas, one factor looms larger than any single breakthrough: regulation. For Unibio’s Eleni Ntokou, it isn’t a barrier but the very architecture of innovation – shaping science, guiding investment, and determining how fast novel proteins can reach global markets
The alternative protein industry has no shortage of bold ideas. Fermentation companies promise to replace animal feed with gas-fed microbes, cultivated meat startups talk about slaughter-free steaks, and plant-based innovators race to perfect the next generation of dairy-free cheese. But as many entrepreneurs have learned, the difference between a prototype and a product on the shelf often comes down to something far less glamorous: regulation.

For Eleni Ntokou, Director of New Product Development, Sustainability & Regulatory Affairs at Unibio – and a speaker at The Future of Protein Production Amsterdam 2025 this month – regulation isn’t the paperwork that follows innovation. It’s the architecture that shapes it. Unibio has spent years pioneering single-cell protein derived from methane gas fermentation, a process designed to produce nutritious, sustainable protein for food and feed at industrial scale. That ambition requires navigating some of the most complex regulatory environments in the world.
“The USA, Europe, and Asia-Pacific all approach novel proteins differently,” she explains. “Some frameworks are fast and flexible, others slow and prescriptive, and many are still finding their footing. You can’t take a one-size-fits-all approach.”
Instead, Unibio designs for the strictest standards, runs submissions in parallel, and works closely with local experts – turning complexity into a roadmap for global growth.

Regulation as a driver, not a hurdle
Many innovators see regulation as a drag on progress, slowing down bold ideas with red tape. Ntokou takes the opposite view. For her, compliance is not just necessary – it is catalytic. “At a very early stage we realized regulation is critical,” she says. “Rather than treating it as an afterthought, we built it into the innovation process from the start.”
That means running regulatory appraisals even at the ideation stage. If a new concept has no feasible pathway or demands insurmountable studies, it never makes it onto the R&D roadmap. Instead, Unibio directs resources to ideas with a clear, science-based path to approval.
“Clear regulatory pathways make innovation more attractive to investors because they see reduced risk and a faster route to market”
By engaging early with frameworks such as EFSA’s guidance in Europe and FDA pathways in the USA, Unibio embeds safety, traceability, and transparency long before a dossier is filed. In practice, that means documenting production parameters from the outset, validating consistency at scale, and generating nutritional and toxicological data early enough to shape the science.
Far from slowing things down, this approach reassures investors. “Clear regulatory pathways make innovation more attractive to investors because they see reduced risk and a faster route to market,” says Ntokou. “It ensures we’re not just creating a breakthrough product, but one that can realistically reach consumers and secure long-term growth.”
Early engagement, smarter strategy
The alternative protein sector often blurs the line between R&D and compliance. A lab breakthrough might look promising, but without regulatory feasibility, it may never become a commercial product. Ntokou’s solution is to treat regulators as partners rather than gatekeepers.
Formal engagement begins once Unibio has a reproducible proof of concept, backed by validated science and initial safety data. By then, regulators are brought into the loop not as a final hurdle but as co-shapers of the development process. “By treating regulation as a partner, we can derisk innovation, guide R&D priorities, and accelerate the path to market,” she says.
This strategy is also about resource management. Regulatory dossiers are notoriously expensive, requiring extensive safety and nutritional studies. To maximize efficiency, Unibio designs studies to meet the expectations of the world’s toughest authorities, such as EFSA and FDA. That way, the same data can be leveraged across multiple jurisdictions without duplication.
External experts are another piece of the puzzle. By working with consultants who specialize in evolving requirements, Unibio avoids costly missteps. “That way we generate high-quality data for submissions and at the same time avoid duplication,” Ntokou notes. It’s a disciplined, strategic approach that helps stretch limited resources while maintaining scientific rigor.

Turning patchwork into opportunity
Regulatory fragmentation is a reality for every company in this space. The USA offers a relatively streamlined GRAS and FDA process, though even that is undergoing change. Europe’s EFSA pathway is more prescriptive and time-consuming, while Asia-Pacific remains a mosaic of diverse requirements.
For Ntokou, the key is turning this patchwork into a strategic driver. Markets with clearer or shorter approval pathways are prioritized, generating early approvals that can then be leveraged in tougher jurisdictions. In parallel, Unibio designs studies to satisfy the strictest standards, ensuring that data packages stand up under scrutiny wherever they’re submitted.
Industry coalitions also matter here. “By working together, companies can pool their voices to engage regulators more effectively, lobby for streamlined approval processes, and advocate for changes that reflect the realities of novel protein technologies,” she says. Trade associations facilitate best practice exchange, build scientific consensus, and help reduce fragmentation across regions.
Harmonization remains a longer-term goal. Initiatives such as Codex Alimentarius – the international food standards body – could, over time, reduce duplication and create more predictable pathways. But Ntokou is realistic: regional tailoring will always be required. “Different markets have unique regulatory cultures, consumer expectations, and risk tolerances,” she points out. The real opportunity lies in designing global strategies flexible enough to adapt locally.
The sandbox effect
If harmonization is the slow burn, sandboxes are the fast fix. Countries like Estonia and Israel have pioneered regulatory sandboxes that allow companies to test novel proteins in controlled, real-world environments while regulators observe closely. For Ntokou, they are “a game-changer”.
“The biggest benefits are twofold,” she explains. “First, they shorten the path to market by providing early feedback on data requirements and potential hurdles. Second, they help de-risk investment by creating a clearer, more predictable environment.” In short, sandboxes foster collaboration between industry and regulators, speeding up innovation without compromising safety.
But there are risks. Testing products before the science is fully mature could damage public trust if problems do arise. That’s why Ntokou emphasizes the need for standards and clear limitations even within a sandbox. Results from one country’s sandbox may also not translate to another regulator’s requirements. “Cross-jurisdictional acceptance is not guaranteed,” she notes, “so companies must still plan carefully for global pathways.”
Asked what a European sandbox might look like, she paints a picture of pre-approved pilot facilities, streamlined requirements aligned with the strictest standards, and access to regulatory experts. Crucially, she’d build in mechanisms for sharing learnings with multiple authorities while safeguarding proprietary information.
Building consumer trust
For Ntokou, transparency is just as important as safety. Even the most elegant regulatory dossier means little if consumers don’t trust the product. That doesn’t mean bombarding people with technical details. Instead, she advocates clear, accessible communication and opportunities for real-world experience.
Controlled tastings, such as those piloted in the Netherlands for cultivated meat, are one way to bridge that gap. By letting consumers sample novel proteins in a safe, regulated environment before full authorization, companies can build familiarity and confidence. Paired with straightforward labeling and educational campaigns, this approach helps demystify complex science.
“Sandboxes foster collaboration between industry and regulators, speeding up innovation without compromising safety”
On the contentious issue of labeling terminology, Ntokou favors simplicity. Terms like ‘fermented protein’ or ‘brewed protein’ are intuitive and consumer-friendly, while technical descriptors like ‘cell-cultured’ risk raising misconceptions. Ingredient disclosures should remain accurate, but front-of-pack language must stay clear, appealing, and easy to process.
Consumer testing remains critical, she adds. Terminology that satisfies regulators or scientists may not resonate with shoppers. The balance lies in ensuring proper disclosure while keeping labels transparent, trustworthy, and accessible.
Evolving frameworks
For now, most regulators are applying frameworks built around traditional foods and additives. The principles – safety, toxicology, allergenicity – still apply, but the methodologies don’t always capture the nuances of microbial fermentation or cell culture.
Ntokou believes the answer is evolution, not replacement. Updated guidance should cover production system validation, molecular characterization, and long-term nutritional impact. At the same time, regulators have an opportunity to modernize their toolbox, using in vitro models and advanced computational methods to reduce reliance on animal testing. That shift would not only align with scientific progress but also protect animal rights while creating more predictable, robust assessments for companies.
Looking ahead
What will define the next five years in alternative proteins? For Ntokou, it won’t be a single technological leap but a regulatory one: the broader adoption of sandboxes. By creating feedback loops where regulation evolves in step with innovation, they have the potential to shorten time to market, reduce risk for investors, and accelerate consumer acceptance.
If she could change just one thing tomorrow, it would be international alignment. “A harmonized fast-track system – or at least mutual recognition of safety data – would eliminate the need to repeat costly studies in every jurisdiction,” she says. “One science-based dossier for all key markets would lower development costs, accelerate adoption, and give consumers worldwide faster access to sustainable protein solutions.”
As she prepares to take the stage at The Future of Protein Production Amsterdam 2025, Ntokou knows the audience will be packed with innovators wrestling with these same questions. Her message to them is clear: regulation is not the enemy of innovation – it is the framework that can turn breakthrough science into trusted products, reaching markets faster, and helping feed a growing world.
Eleni Ntokou is one of more than 100 speakers taking to the stage at The Future of Protein Production Amsterdam on 29/30 October 2025. To join her and more than 1,000 other attendees, book your conference ticket today and use the code, 'PPTI10', for an extra 10% discount on the current rate. Click here
If you have any questions or would like to get in touch with us, please email info@futureofproteinproduction.com




